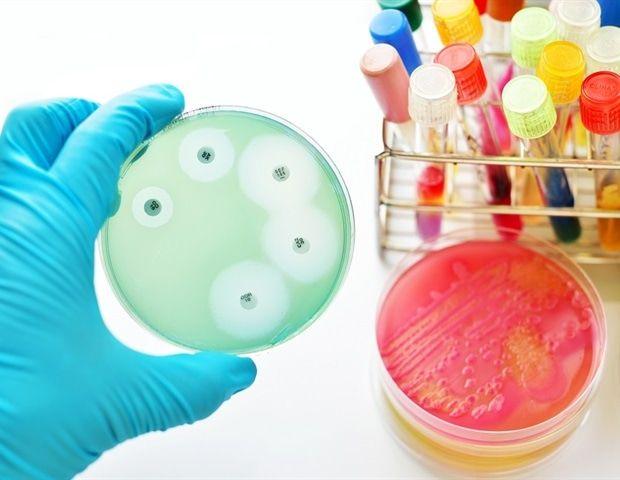
Source: News-Medical

2 Sources
2 Sources
[1]
New method uses exosome stiffness for lung cancer gene detection
DGISTJul 30 2025 The research team led by Senior Researchers Yoonhee Lee from the Division of Biomedical Technology and Gyogwon Koo from the Division of Intelligent Robot at DGIST (under President Kunwoo Lee) has developed a technology that distinguishes lung cancer gene mutations solely by measuring the "stiffness" of exosomes-tiny particles released from cancer cells in the bloodstream-using atomic force microscopy (AFM). Their study enables rapid and precise analysis of individual exosomes and is expected to advance into a new liquid biopsy-based diagnostic technique for lung cancer. Non-small cell lung cancer (NSCLC) is the most common type of lung cancer, accounting for more than 85% of all cases. However, because it rarely shows noticeable symptoms in the early stages, it is often diagnosed at an advanced stage, making treatment difficult. NSCLC continues to have a high mortality rate, and developing new diagnostic technologies that enable early detection and treatment remains a significant challenge in the medical field. In particular, conventional tissue biopsies place a considerable burden on patients and have limitations in repeated testing. As such, non-invasive liquid biopsy technology utilizing blood-derived information has recently attracted attention. The research team led by Senior Researchers Yoonhee Lee and Gyogwon Koo at DGIST isolated exosomes from NSCLC cell lines with distinct genetic mutations (A549: KRAS mutation, PC9: EGFR mutation, PC9/GR: EGFR-resistant mutation). Using AFM, the team measured nano-scale physical properties of individual exosomes at high resolution, including surface stiffness and height-to-radius ratios. They found that the exosomes derived from A549 cells exhibited significantly higher stiffness, which indicated that alterations in the cell membrane lipids caused by KRAS mutations were also reflected in the exosomes. In contrast, exosomes derived from PC9 and PC9/GR cells showed similar properties, suggesting a correlation with their shared genetic background. These findings demonstrate that the physical properties of exosomes vary depending on the genetic mutations of the cancer cells from which they originate. To precisely classify these nanomechanical characteristics of exosomes, the research team employed AI technology. Height and stiffness data of exosomes obtained through AFM were visualized and used to train a deep learning-based convolutional neural network (DenseNet-121) model to classify their cell lines of origin. Exosomes derived from A549 cells were distinguished with a remarkably high accuracy of 96%, and the overall average AUC reached 0.92. This demonstrates the potential of a next-generation liquid biopsy platform capable of high-precision classification based solely on the physical properties of exosomes, without the need for fluorescent labeling. Senior Researchers Yoonhee Lee and Gyogwon Koo stated, "This study presents a new diagnostic potential to distinguish lung cancer with specific genetic mutations using only a small amount of exosome samples. We plan to actively pursue the practical application of this technology by integrating a high-speed AFM platform in clinical sample validation." DGIST Journal reference: Park, S., et al. (2025). Deep Learning-Based Classification of NSCLC-Derived Extracellular Vesicles Using AFM Nanomechanical Signatures. Analytical Chemistry. doi.org/10.1021/acs.analchem.5c02009
[2]
AI detects the stiffness of cancer cell exosomes, enhancing lung cancer diagnostic accuracy
A research team has developed a technology that distinguishes lung cancer gene mutations solely by measuring the "stiffness" of exosomes -- tiny particles released from cancer cells in the bloodstream -- using atomic force microscopy (AFM). The study enables rapid and precise analysis of individual exosomes and is expected to advance into a new liquid biopsy-based diagnostic technique for lung cancer. The research findings were published online in Analytical Chemistry. Non-small cell lung cancer (NSCLC) is the most common type of lung cancer, accounting for more than 85% of all cases. However, because it rarely shows noticeable symptoms in the early stages, it is often diagnosed at an advanced stage, making treatment difficult. NSCLC continues to have a high mortality rate, and developing new diagnostic technologies that enable early detection and treatment remains a significant challenge in the medical field. In particular, conventional tissue biopsies place a considerable burden on patients and have limitations in repeated testing. As such, non-invasive liquid biopsy technology utilizing blood-derived information has recently attracted attention. The research team, led by Senior Researchers Yoonhee Lee from the Division of Biomedical Technology and Gyogwon Koo from the Division of Intelligent Robot at DGIST, isolated exosomes from NSCLC cell lines with distinct genetic mutations (A549: KRAS mutation, PC9: EGFR mutation, PC9/GR: EGFR-resistant mutation). Using AFM, the team measured nano-scale physical properties of individual exosomes at high resolution, including surface stiffness and height-to-radius ratios. They found that the exosomes derived from A549 cells exhibited significantly higher stiffness, which indicated that alterations in the cell membrane lipids caused by KRAS mutations were also reflected in the exosomes. In contrast, exosomes derived from PC9 and PC9/GR cells showed similar properties, suggesting a correlation with their shared genetic background. These findings demonstrate that the physical properties of exosomes vary depending on the genetic mutations of the cancer cells from which they originate. To precisely classify these nanomechanical characteristics of exosomes, the research team employed AI technology. Height and stiffness data of exosomes obtained through AFM were visualized and used to train a deep learning-based convolutional neural network (DenseNet-121) model to classify their cell lines of origin. Exosomes derived from A549 cells were distinguished with a remarkably high accuracy of 96%, and the overall average AUC reached 0.92. This demonstrates the potential of a next-generation liquid biopsy platform capable of high-precision classification based solely on the physical properties of exosomes, without the need for fluorescent labeling. Yoonhee Lee and Gyogwon Koo stated, "This study presents a new diagnostic potential to distinguish lung cancer with specific genetic mutations using only a small amount of exosome samples. We plan to actively pursue the practical application of this technology by integrating a high-speed AFM platform in clinical sample validation."
Share
Share
Copy Link
Researchers at DGIST have developed an AI-driven method to detect lung cancer gene mutations by measuring exosome stiffness, potentially transforming early diagnosis and treatment of non-small cell lung cancer.
Researchers at the Daegu Gyeongbuk Institute of Science and Technology (DGIST) have developed a groundbreaking method for detecting lung cancer gene mutations by analyzing the stiffness of exosomes using artificial intelligence (AI) and atomic force microscopy (AFM). This innovative approach could revolutionize early diagnosis and treatment of non-small cell lung cancer (NSCLC), the most common form of lung cancer
1
2
.NSCLC accounts for over 85% of all lung cancer cases and is often diagnosed at advanced stages due to a lack of early symptoms. This late detection contributes to high mortality rates, making the development of new diagnostic technologies a critical challenge in oncology
1
2
.The research team, led by Senior Researchers Yoonhee Lee and Gyogwon Koo, focused on exosomes - tiny particles released by cancer cells into the bloodstream. Using AFM, they measured nano-scale physical properties of individual exosomes, including surface stiffness and height-to-radius ratios
1
2
.
Source: Medical Xpress
Key findings include:
These results suggest that exosome physical properties correlate with the genetic mutations of their originating cancer cells
1
2
.To classify the nanomechanical characteristics of exosomes precisely, the team employed a deep learning-based convolutional neural network (DenseNet-121) model. The AI was trained on height and stiffness data obtained through AFM
1
2
.The results were impressive:
This high-precision classification was achieved based solely on the physical properties of exosomes, without the need for fluorescent labeling
1
2
.Related Stories
Conventional tissue biopsies are invasive and have limitations for repeated testing. The new liquid biopsy technique offers several advantages:
Source: News-Medical
The researchers believe this study presents new diagnostic potential for distinguishing lung cancer with specific genetic mutations using only small exosome samples. They plan to pursue practical applications by integrating a high-speed AFM platform in clinical sample validation
1
2
.This technology could lead to:
As the field of liquid biopsy continues to advance, this AI-powered exosome analysis technique may play a crucial role in transforming lung cancer diagnostics and improving patient outcomes
1
2
.Summarized by
Navi
[1]
11 Jul 2025•Science and Research

27 Mar 2025•Health

15 Nov 2024•Health
